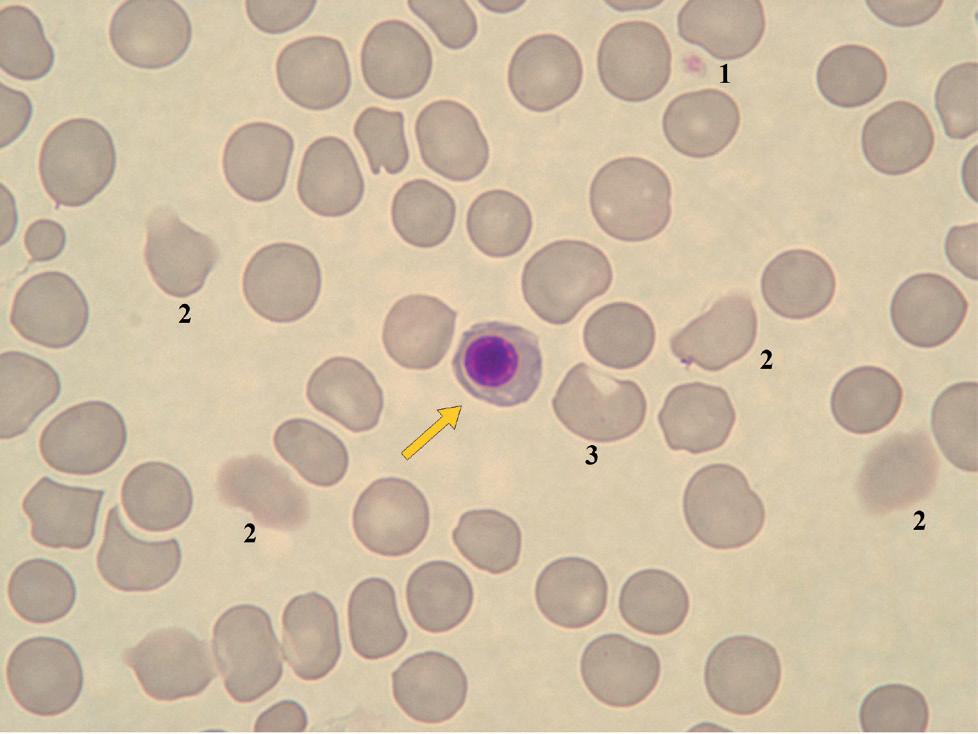
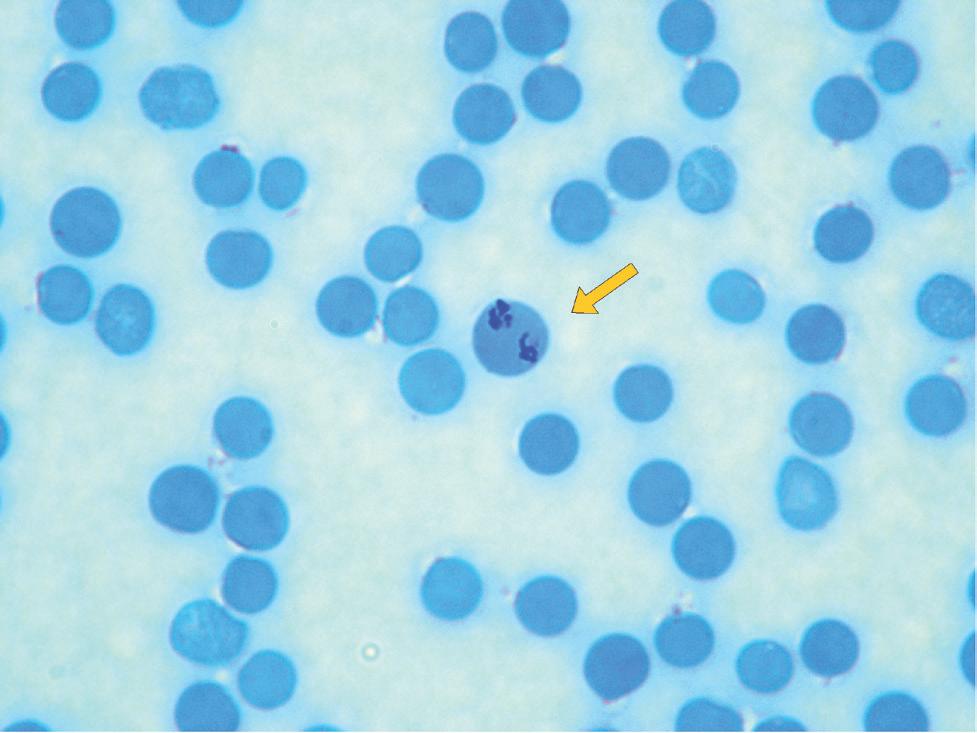
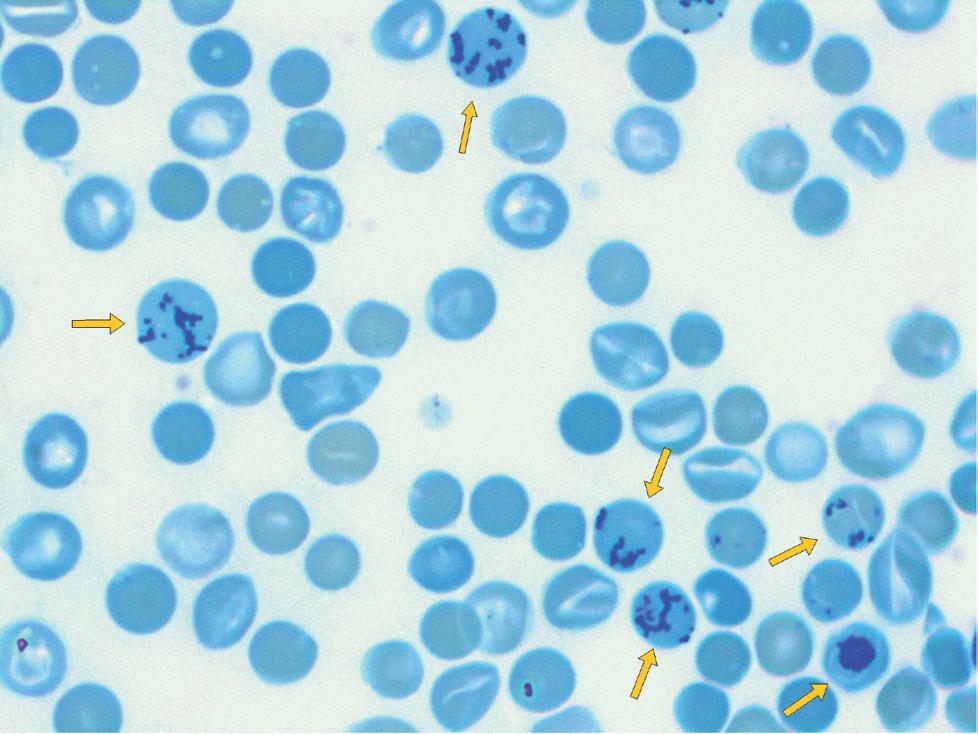
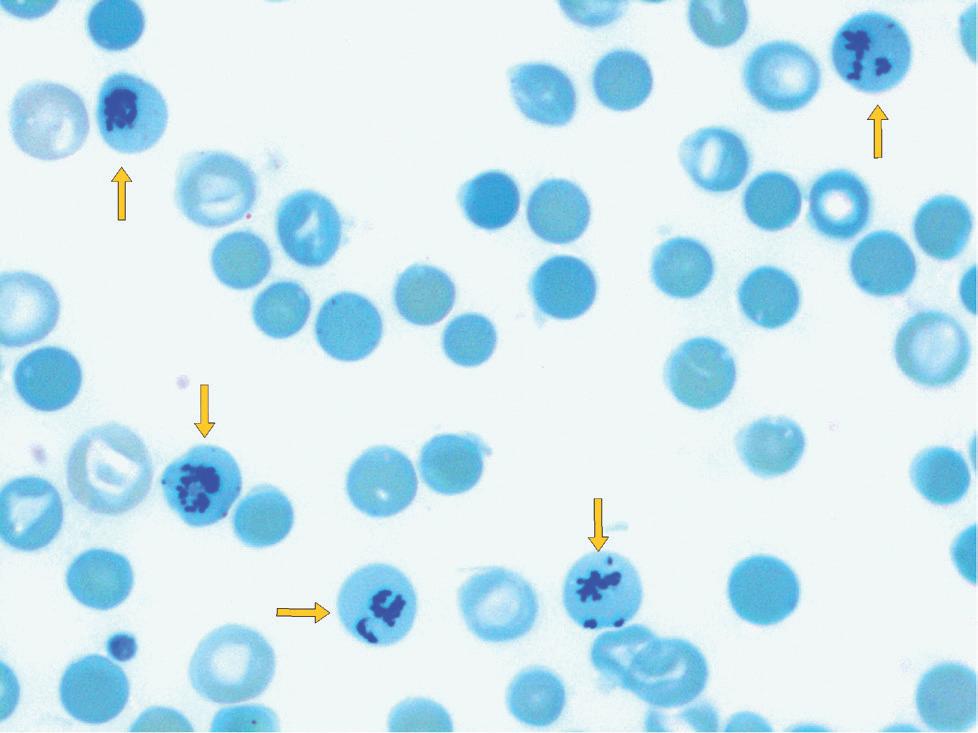
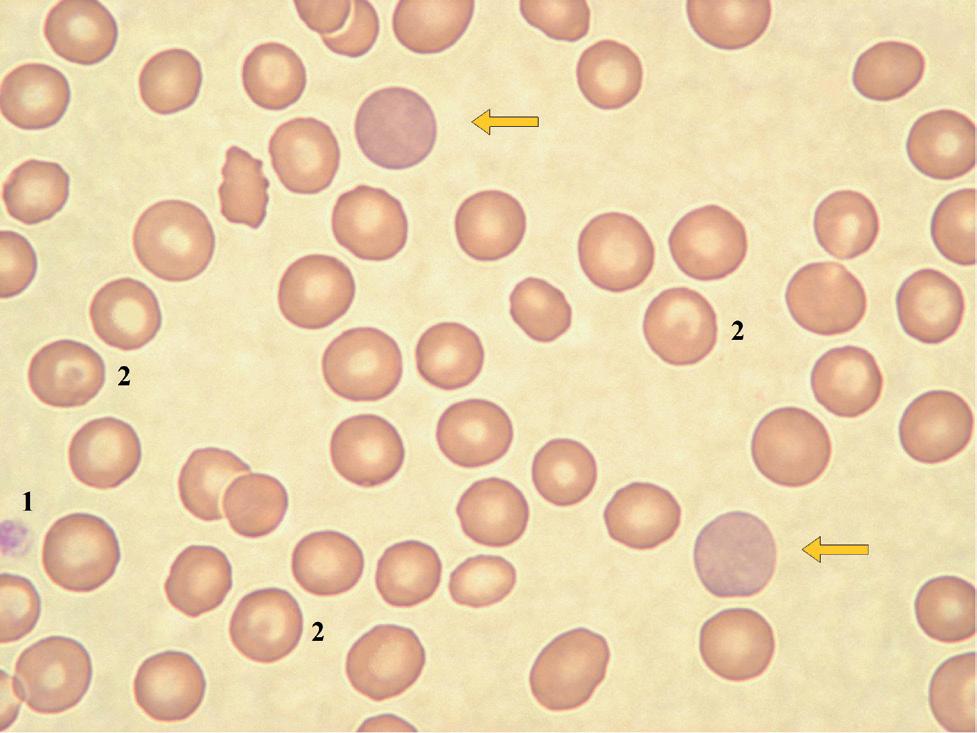
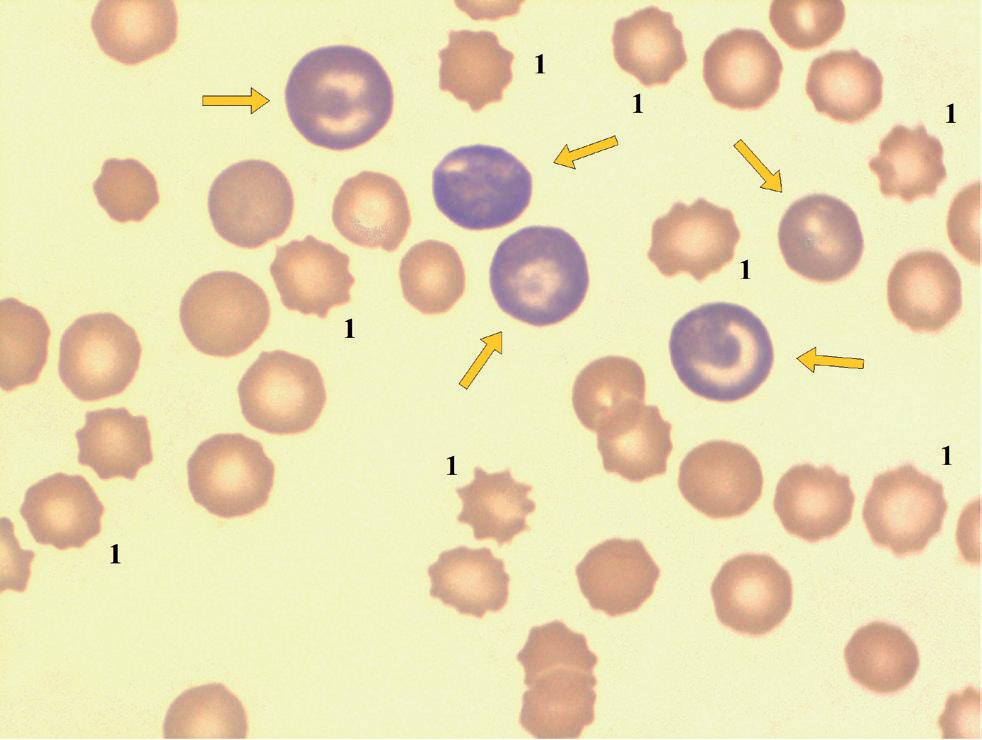
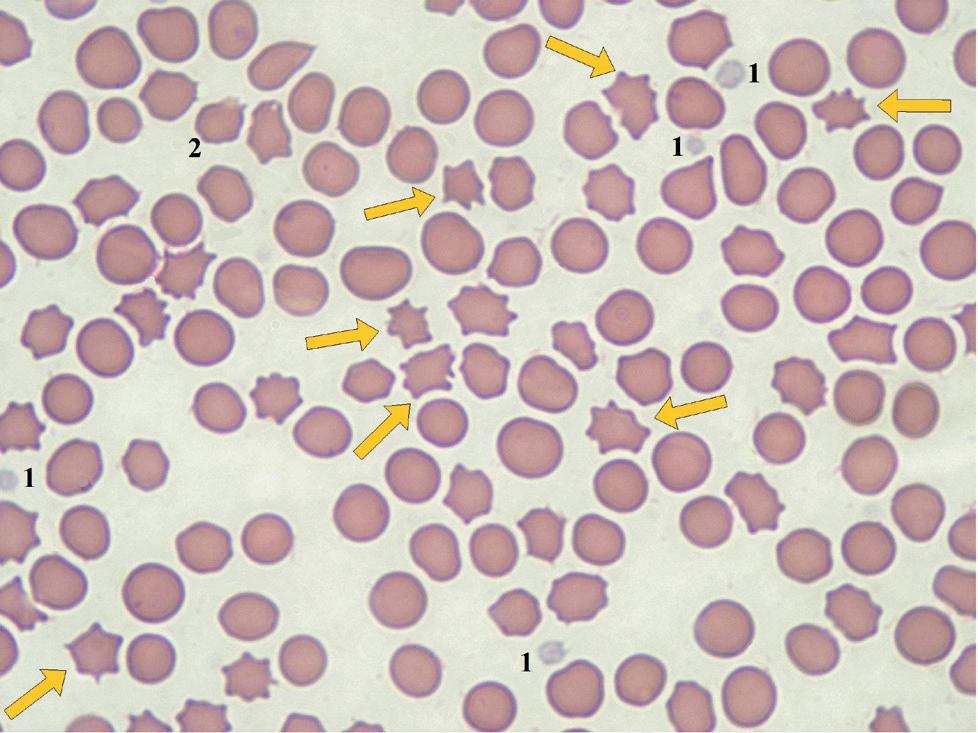
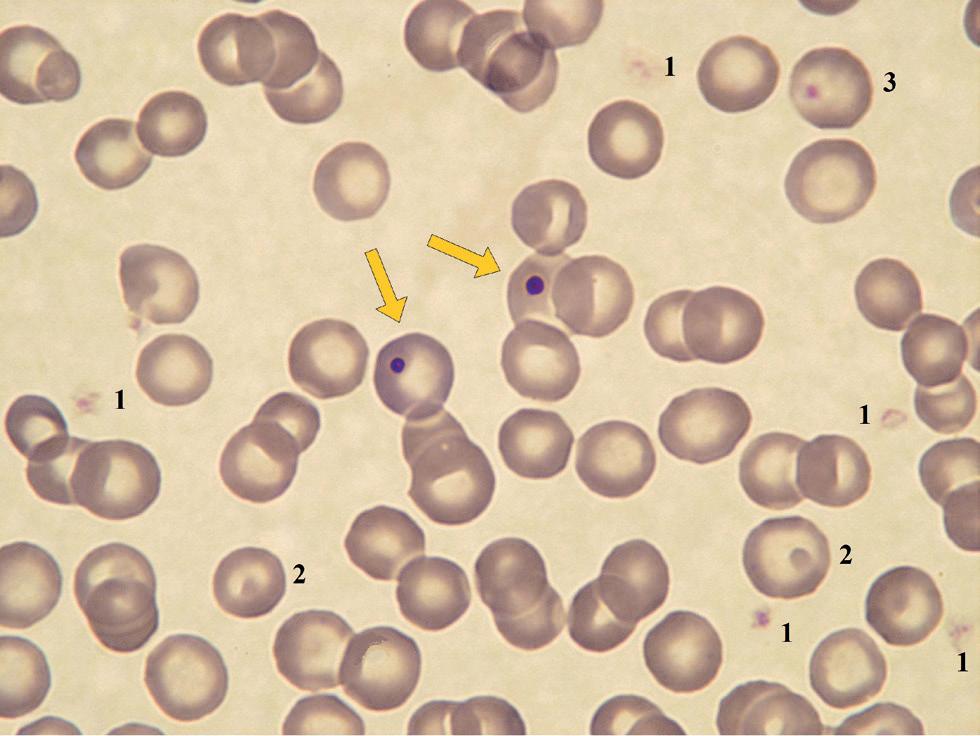

ATLAS hematologiczny psów i kotów

![]()

Andrzej Degórski Anna Winnicka
© Copyright tekstu i rycin Andrzej Degórski, Anna Winnicka
© Copyright by Galaktyka sp. z o.o., Łódź 2013
Doktor Andrzej Degórski
Profesor dr hab. Anna Winnicka, Zakład Patologii Zwierząt, Katedra Patologii i Diagnostyki
Weterynaryjnej, Instytut Medycyny Weterynaryjnej, Szkoły Głównej Gospodarstwa Wiejskiego w Warszawie
Galaktyka sp. z o.o.
90-644 Łódź, ul. Żeligowskiego 35/37
tel.: 42 639 50 18, tel./fax 42 639 50 17 e-mail: weterynaria@galaktyka.com.pl www.galaktyka.com.pl
Zdjęcie okładkowe: © Sashkinw – Istock.com
Redakcja naukowa: prof. dr hab. Roman Lechowski
Redakcja językowa: Marta Sobczak
Korekta: Monika Ulatowska
Redakcja techniczna: Marta Sobczak
Koordynacja projektu: Marta Sobczak
Projekt okładki: Garamond
Skład: Garamond
Druk: Mazowieckie Centrum Poligrafii
ISBN: 978-83-7579-947-7
Wydanie III, dodruk 2025
Medycyna jest gałęzią nauki cechującą się stałym rozwojem wiedzy. Badania naukowe i trwały postęp w klinicznych metodach postępowania wywierają także wpływ na farmakoterapię. Autorzy niniejszej książki starali się przedstawić dokładne informacje i wskazówki dotyczące dawkowania różnych leków przy odpowiednim zastosowaniu oraz w zgodzie z aktualnym stanem wiedzy. Te wskazówki dawkowania są zgodne ze standardowymi przepisami i wskazaniami producentów. Mimo to ani autorzy, ani wydawnictwo nie mogą gwarantować prawidłowości dawkowania. Lekarzom praktykującym zaleca się, aby w każdym przypadku stosowania leków uwzględniali informacje producenta odnośnie do dawkowania i przeciwwskazań. Jest to szczególnie ważne w przypadku preparatów rzadko używanych lub nowych na rynku. Każde dawkowanie lub podanie leku odbywa się na własne ryzyko czytelnika. Przy stosowaniu leków u zwierząt, które służą do produkcji żywności, należy przestrzegać przepisów dotyczących dopuszczenia leków i ograniczeń w ich stosowaniu, które są różne w poszczególnych krajach. Podanie w niniejszej książce nazw użytkowych, nazw handlowych, oznakowań towarów itp. nie uprawnia do przypuszczeń, że takie nazwy można uznać za wolne w sensie ustawodawstwa o znakach fabrycznych i o ochronie prawnej znaków fabrycznych, czyli takie, których każdy może dowolnie używać.
Zachowania zwierząt nigdy nie można przewidzieć, dlatego zawsze zalecamy zastosowanie odpowiednich środków ostrożności podczas pracy ze zwierzętami.
Autorzy i wydawca dołożyli wszelkich starań, aby zawarte w tej książce informacje były rzetelne i kompletne, nie ponoszą jednak żadnej odpowiedzialności za mogące pojawić się błędy, nieścisłości, przeoczenia lub niezgodności, ani za szkody i straty powstałe w wyniku stosowania informacji zawartych w niniejszej publikacji.
W szeregu czerwonokrwinkowym jest to etap pośredni pomiędzy erytroblastem wielobarwliwym a retikulocytem, w który przekształca się po odrzuceniu jądra. Wielkość komórki: średnica 7–10 µm.
Kształt komórki: okrągły lub nieco owalny.
Jądro: okrągłe i pyknotyczne; chromatyna silnie zagęszczona i bardzo ciemna.
Cytoplazma: niebieskawo-różowa do różowo-pomarańczowej z pasmami przejaśnień.
Stosunek powierzchni jądro/cytoplazma: ok. 1 : 1,5.
Występowanie: w szpiku. We krwi – prawidłowo brak. Mogą towarzyszyć nasilonej wielobarwliwości w niedokrwistościach regeneratywnych; pojawiają się także we krwi po podaniu erytropoetyny, po złamaniach kości, urazach lub usunięciu śledziony oraz po jej krótkotrwałym skurczu (silne pobudzenie emocjonalne, znaczny wysiłek). Bez wielobarwliwości – jako wczesny objaw w niedokrwistości przedregeneratywnej po znacznej utracie krwi lub hemolizie, w zatruciu ołowiem (z nakrapianiem zasadochłonnym i niedobarwliwością), chorobach rozrostowych szpiku, martwicy szpiku, w erytropoezie pozaszpikowej, posocznicy, w przerzutach nowotworowych do szpiku oraz u kotów w przebiegu zakażenia FeLV.
Barwienie: MGG.
Powiększenie: 1000×.
Rycina 14. Erytroblast kwasochłonny (strzałka) we krwi obwodowej kota. Anizocytoza. 1 – płytka krwi, 2 – rozpadające się erytrocyty (artefakty), 3 – keratocyt
Są to bezjądrzaste, ale jeszcze nie w pełni dojrzałe, krwinki czerwone z niezakończoną syntezą hemoglobiny. W szeregu czerwonokrwinkowym jest to etap pośredni pomiędzy erytroblastem kwasochłonnym a dojrzałym erytrocytem. W praktyce laboratoryjnej termin „retikulocyt” zwykle wiąże się z wyglądem niedojrzałych bezjądrzastych erytrocytów wcześniej przyżyciowo zabarwionych błękitem brylantowo-krezylowym lub nowym błękitem metylenowym (barwienie wykonywane w celu dokładnego oznaczenia liczby retikulocytów we krwi). Te same krwinki widoczne w rozmazach krwi rutynowo barwionych metodą MGG zwyczajowo są nazywane polichromatofilami (zob. Zmiany w wybarwieniu oraz hasło wielobarwliwość w Słowniczku).
Wielkość komórki: większe od dojrzałych erytrocytów, średnica: u psa 7–10 µm, u kota 6–9 µm.
Jądro: brak.
Cytoplazma: szaroniebieska, skupiska rybosomów z RNA w postaci ziarnisto-nitkowatych agregatów (u psów wszystkie, u kotów – retikulocyty agregatowe) lub pojedynczych punktów (retikulocyty punktowe u kotów) zabarwionych intensywnie na ciemnoniebiesko lub nawet na granatowo.
Występowanie: szpik, krew (prawidłowo – u psa: 0–1%, u kota 0–0,6% retikulocytów agregatowych), wzrost liczby przy niedokrwistościach regeneratywnych.
Barwienie: przyżyciowe, przed wykonaniem rozmazu, za pomocą błękitu brylantowo-krezylowego.
Powiększenie: 1000×.
Rycina 19. Retikulocyt (strzałka) w rozmazie krwi obwodowej psa zabarwionej przyżyciowo błękitem brylantowo-krezylowym
Rycina 20. Retikulocyty (strzałki) w rozmazie krwi psa po przyżyciowym zabarwieniu błękitem brylantowo-krezylowym. Anizo- i poikilocytoza
Rycina 21. Pięć retikulocytów (strzałki) w rozmazie krwi psa zabarwionej błękitem brylantowo-krezylowym. Widoczna anizo- i poikilocytoza
Retikulocyty w rutynowo barwionych rozmazach krwi zwane są polichromatofilami ze względu na odmienny od dojrzałych erytrocytów, bardziej zasadochłonny sposób ich barwienia się na kolor niebieskawo-pomarańczowy. Tak barwią się w rozmazie wszystkie retikulocyty psów, natomiast u kotów jedynie retikulocyty agregatowe.
Wielkość komórki: zwykle są one makrocytami; średnica u psa 7–10 µm, u kota 6–9 µm.
Kształt komórki: mniej lub bardziej dwuwklęsły dysk, a przy pośpiesznej i nasilonej erytropoezie towarzyszącej znacznej utracie krwi lub hemolizie mogą przyjmować kształt krwinek tarczowatych lub stomatocytów.
Występowanie: u psa prawidłowo 0–1% wszystkich krwinek czerwonych, u kota 0–0,6% (zob. tab. 1). Liczba polichromatofili we krwi istotnie zwiększa się w niedokrwistościach regeneratywnych.
Barwienie: MGG.
Powiększenie: 1000×.
Rycina 41. Polichromatofile (strzałki) we krwi obwodowej psa z niedokrwistością. 1 – płytka krwi, 2 – krwinki tarczowate
Rycina 42. Różnokształtne polichromatofile (strzałki) we krwi obwodowej psa ze znaczną niedokrwistością.
1 – echinocyty

Rycina 43. Liczne polichromatofile (strzałki) we krwi psa z niedokrwistością regeneratywną. Także znaczna anizo- i poikilocytoza.
1 – płytki krwi, 2 – echinocyty, 3 – akantocyty, 4 – krwinki tarczowate, 5 – makrocyt
Poikilocyty z kilkoma (od 2 do 10) wydłużonymi palczastymi wypustkami błony komórkowej o nieregularnym kształcie i różnej długości. W erytrocycie zwykle brak środkowego przejaśnienia.
Występowanie: akantocytoza jest nieswoistym objawem w zaburzeniach gospodarki lipidowej (choroby wątroby, w tym zespolenie wrotno-główne, choroby nerek) oraz z fragmentocytami i keratocytami w mikroangiopatiach związanych z rozsianym krzepnięciem wewnątrznaczyniowym, naczyniakomięsakami krwionośnymi wątroby, śledziony i serca u psów oraz śledziony u kotów.
Barwienie: MGG.
Powiększenie: 1000×.

Rycina 67. Akantocyty (strzałki) we krwi psa z niedokrwistością regeneratywną. Widoczna anizo- i poikilocytoza oraz poli- i hipochromazja. 1 – polichromatofile, 2 – keratocyt, 3 – rozpadający się erytrocyt, 4 – stomatocyt, 5 – echinocyty

Rycina 68. Liczne akantocyty (kilka z nich zaznaczono strzałkami) we krwi obwodowej psa z naczyniakomięsakiem krwionośnym śledziony. Anizocytoza, znaczna poikilocytoza, silna wielobarwliwość i niedobarwliwość.
1 – płytka krwi, 2 – polichromatofile, 3 – stomatocyt
Rycina 69. Akantocyty (strzałki) we krwi kota.
1 – płytki krwi, 2 – erytrocyt z ciałkiem Heinza
Małe (1–2 µm), ciemnofioletowe, pojedyncze – rzadziej podwójne, kuliste, wyraźnie odgraniczone pozostałości po jądrze erytroblastu, widoczne w cytoplazmie polichromatofili lub dojrzałych erytrocytów.
Występowanie: u kotów mogą występować fizjologicznie w pojedynczych erytrocytach w rozmazie. Obecność we krwi psów i zwiększona liczba we krwi kotów często towarzyszy znacznie nasilonej i przyśpieszonej erytropoezie przy niedokrwistościach regeneratywnych. Zwiększona liczba erytrocytów z ciałkami Howella-Jolly’ego może pojawić się we krwi również po podaniu erytropoetyny, w czasie leczenia glikokortykosteroidami, w erytropoezie pozaszpikowej, w chorobach śledziony lub po jej usunięciu.
Barwienie: MGG.
Powiększenie: 1000×.
Rycina 97. Ciałka Howella-Jolly’ego w erytrocytach (strzałki) psa. 1 – płytki krwi, 2 – krwinki tarczowate, 3 – obecność ciałka wtrętowego w erytrocycie imituje leżąca pod nim płytka krwi
aglutynacja – zlepianie erytrocytów przez przeciwciała (głównie klasy IgM) skierowane przeciwko antygenom własnym erytrocytów, znajdującym się na ich powierzchni lub we wnętrzu. Może być widoczna gołym okiem w próbce (bardzo rzadko) lub tylko pod mikroskopem. Jest to jeden z objawów patognomonicznych niedokrwistości hemolitycznej tła immunologicznego. agranulocyty – grupa leukocytów, do której zalicza się limfocyty i monocyty.
akantocyt – erytrocyt o nieprawidłowym kształcie z kilkoma (2–10) wydłużonymi palczastymi wypustkami błony komórkowej o różnym kształcie i różnej długości. Akantocytoza jest nieswoistym objawem chorób prowadzących do zaburzeń gospodarki lipidowej. anemia – zob. niedokrwistość. anizocytoza – jednoczesna obecność we krwi erytrocytów o różnej wielkości – obok normocytów występują mikrocyty i/lub makrocyty. Termin stosowany także w odniesieniu do płytek krwi. babeszjoza – choroba psów wywołana inwazją przenoszonego przez kleszcze pierwotniaka Babesia canis pasożytującego w erytrocytach, który może doprowadzić do ciężkiej niedokrwistości hemolitycznej tła immunologicznego.
bazofil – granulocyt zasadochłonny.
bazofilia – zwiększenie liczby granulocytów zasadochłonnych we krwi krążącej, jest to niestały objaw przy uogólnionych reakcjach nadwrażliwości (rozpoznawanie – zob. tab. 3).
białaczka (leukemia) – nowotworowy rozplem komórek pochodzenia szpikowego, które zwykle uwalniane są do krwi.
-cytoza – w wyrazach złożonych z nazwą krwinki przyrostek oznaczający zwiększenie liczby tego rodzaju krwinek we krwi obwodowej.
ciałko Barra – (ciałko X, „pałeczka dobosza”) w granulocytach pałeczkowatych samic pojedyncze, rzadziej podwójne, skupisko chromatyny płciowej w postaci wyodrębnionego niewielkiego płata jądra o kulistym kształcie.
ciałko Döhle’go – ciemnoniebieskie skupisko zagregowanych pozostałości rybosomalnego RNA w cytoplazmie granulocytów obojętnochłonnych, jedna ze zmian toksycznych w neutrofilach.
ciałko Heinza – grudka zdenaturowanej i wytrąconej hemoglobiny uwypuklająca błonę komórkową erytrocytu. Ciałka Heinza u kotów są większe i wyraźniejsze. Efekt działania na globinę związków o właściwościach silnie utleniających.
ciałko Howella-Jolly’ego – mała (1–2 µm), kulista, pojedyncza (rzadziej podwójna), wyraźnie odgraniczona, barwiąca się silnie zasadowo pozostałość po jądrze erytroblastu widoczna w cytoplazmie polichromatofili lub dojrzałych erytrocytów. Erytrocyty z ciałkami Howella-Jolly’ego w zwiększonej liczbie mogą pojawiać się w czasie nasilonej bądź zaburzonej erytropoezy. cienie erytrocytów (ang. ghost cells) – erytrocyty pozbawione hemoglobiny, pojawiające się we krwi obwodowej przy nasilonej hemolizie zewnątrznaczyniowej. echinocyt – erytrocyt o nieprawidłowym kształcie z licznymi, krótkimi wypustkami błony komórkowej o regularnym kształcie i długości, które nadają obrysowi komórki wygląd koła zębatego. Najczęściej spotykane są jako artefakty zwane krenocytami. W stanach patologicznych echinocyty mogą być nieswoistym objawem poważnych zaburzeń metabolicznych. ekscentrocyt – erytrocyt o nieprawidłowym kształcie z niesymetrycznie ułożoną hemoglobiną na skutek uszkodzenia błony komórkowej przez substancję silnie utleniającą. eliptocyt – zob. owalocyt.
Atlas hematologiczny psów i kotów autorstwa dr. Andrzeja Degórskiego i prof. dr hab. Anny Winnickiej jest pierwszą tego rodzaju, zwartą pozycją w polskiej literaturze poświęconej diagnostyce hematologicznej. Szczególną wartość tego opracowania stanowią imponująca ikonografia oraz bardzo dokładne, wręcz dydaktyczne, opisy prezentowanych rycin. Książka jest swego rodzaju podręcznikiem dla wszystkich praktykujących lekarzy weterynarii, którzy zajmują się psami i kotami, a także nieocenioną pomocą dla studentów medycyny weterynaryjnej. Powinna również znaleźć się w biblioteczce wszystkich osób zawodowo zajmujących się weterynaryjną diagnostyką laboratoryjną.
prof. dr hab. Roman Lechowski

W tej książce znajdziesz:
• prezentację prawidłowych oraz najczęściej spotykanych patologicznych postaci krwinek czerwonych, krwinek białych i płytek krwi,
• opis najtrudniejszej części badania hematologicznego, która wiąże się z przygotowaniem, barwieniem i oglądaniem rozmazu krwi oraz interpretacją uzyskanych wyników,
• zakresy wartości referencyjnych oraz tabele pozwalające na zdefiniowanie poszczególnych zaburzeń w układzie czerwono- i białokrwinkowym,
• praktyczny słowniczek, w którym uwzględniono podstawowe pojęcia stosowane w hematologii weterynaryjnej.
ISBN: 978-83-7579-947-7
www.galaktyka.com